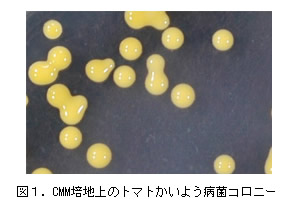

| [成果情報名] | トマトかいよう病菌選択培地CMM培地を用いた種子検定法 |
| [要約] | トマトかいよう病菌選択培地CMM培地を用いると、施設栽培での全身感染株から採種したミニトマト種子よりトマトかいよう病菌(Clavibacter michiganensis subsp. michiganensis)を検出することが可能である。 |
| [キーワード] | トマトかいよう病、種子検定、CMM培地 |
| [担当] | 和歌山農総セ・農試・環境部 |
| [連絡先] | 電話 0736-64-2300 |
| [区分] | 近畿中国四国農業・生産環境(病害虫) |
| [分類] | 研究・参考 |
[具体的データ]

|
 |
| [その他] | ||
| 研究課題名 | : | 生産安定のための病害虫緊急防除対策 |
| 予算区分 | : | 県単 |
| 研究期間 | : | 2005~2007年度 |
| 研究担当者 | : | 大谷洋子、岡本晃久、増田吉彦 |